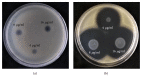

The Green Synthesis of MgO Nano-Flowers Using Rosmarinus officinalis L. (Rosemary) and the Antibacterial Activities against Xanthomonas oryzae pv. oryzae
- PMID: 30906776
- PMCID: PMC6398066
- DOI: 10.1155/2019/5620989
The Green Synthesis of MgO Nano-Flowers Using Rosmarinus officinalis L. (Rosemary) and the Antibacterial Activities against Xanthomonas oryzae pv. oryzae
Abstract
Recently, the use of herbs in the agriculture and food industry has increased significantly. In particular, Rosmarinus officinalis L. extracts have been reported to have strong antibacterial properties, which depend on their chemical composition. The present study displayed a biological method for synthesis of magnesium oxide (MgO) nano-flowers. The nano-flowers are developed without using any catalyst agent. Aqueous Rosemary extract was used to synthesize MgO nano-flowers (MgONFs) in stirring conditions and temperature at 70°C for 4 h. The mixture solution was checked by UV-Vis spectrum to confirm the presence of nanoparticles. The MgO nano-flowers powder was further characterized in this study by the X-ray diffraction, scanning electron microscopy, transmission electron microscopy, and Fourier transform infrared spectroscopy. In addition, bacteriological tests indicated that MgO nano-flowers significantly inhibited bacterial growth, biofilm formation, and motility of Xanthomonas oryzae pv. oryzae, which is the causal agent of bacterial blight disease in rice. The electronic microscopic observation showed that bacterial cell death may be mainly due to destroy of cell integrity, resulting in leakage of intracellular content. As recommended, the use of Rosemary extract is an effective and green way to produce the MgO nano-flowers, which can be widely used in agricultural fields to suppress bacterial infection.
Figures

References
-
- Okitsu K., Mizukoshi Y., Yamamoto T. A., Maeda Y., Nagata Y. Sonochemical synthesis of gold nanoparticles on chitosan. Materials Letters. 2007;61(16):3429–3431. doi: 10.1016/j.matlet.2006.11.090. - DOI
MeSH terms
Substances
LinkOut - more resources
Full Text Sources
Other Literature Sources
Medical
Research Materials

